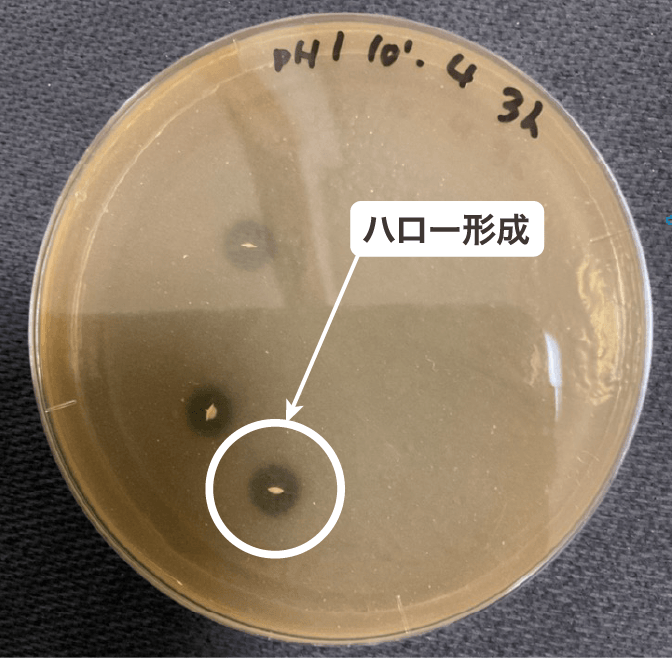

今続けている菌活
実際こんな事ありませんか?
菌活あるある
チェックシート
- 情報が多すぎて、結局どれが良いのかわからない
- なんとなく続けてるけど、正直「これで良いの?」と思うことがある
- 今試している菌活食品の糖分やカロリーが気になる…
- 菌活しているのに、いまだに「パパの後のトイレ嫌!」って…
- 長く続ける自信がない
人によって
必要な菌の種類が
違う!?
単体の菌での菌活だと
体感性が低いかも!?
そんなあなたは
菌の多様性
が足りてないかもしれません
体内フローラの
祖先!?
土壌菌に着目
土壌中で行われている植物の根と菌類の共生は人間の腸と腸内細菌の関係性に似ています。健全な土壌と健康な体のどちらも微生物の多様性が重要であると言われています。

ソイルキュアは
自然界から受け継いだ菌群の多様性を崩さずに有用菌を
選別しました
弊社のプロバイオティクス
土壌細菌群
SBO(Soil Bacteria Okinawa)
こんなデータが取れています。
人工胃液ならびに人工腸液での生残性が確認されたことから
SOILcureは
“プロバイオティクス”
としての適用性を
確認しています。
1

今話題の短鎖脂肪酸を作り出す、
短鎖脂肪酸産生菌群含有
細菌が短鎖脂肪酸を産生した場合、培地中の炭酸カルシウム(白色)が溶解し、コロニーの周囲に透き通った『ハロー』を形成します。
SOILcureの人工消化液中での生残性試験の結果、含まれる有用菌群が増殖する過程で短鎖脂肪酸(酢酸、プロピオン酸、イソ酪酸、吉草酸、イソ吉草酸等)を産生していることが判明しています。
2

有用菌群(短鎖脂肪酸生産菌群)が生きて腸まで届く

人工胃液耐性試験における異なるpHでの生数の比較(生菌数測定は、嫌気性培養による)
本製品に含まれる土壌由来細菌群は、pH1.0の条件(空腹時を想定)にて1時間後に43.7%、3時間後でも3.1%生存していることが明らかとなっています。
人工腸液(0.2% Ox Gall)で3時間培養しても短鎖脂肪酸産生菌が生存することを確認しています。
今注目の健康サポート物質
「短鎖脂肪酸」って?

素材は
すべて沖縄産。
そして
Made in Okinawa



安全性について
- 第三者機関による食品安全検査を実施
- ロット毎の微生物試験を実施
- 製造工場においてHACCPの考えを取り入れた衛生管理を実施し、専門家および第三者機関のサポートを受けて取り組んでいます。
- 定期的な食品安全検査の実施
最終製品の全てのロットにおいて、第三者機関による食品安全検査を実施し、大腸菌や食中毒菌として知られるセレウス菌・サルモネラ菌・緑膿菌・黄色ブドウ球菌が陰性であること、水分活性が0.6以下であることを確認して出荷しております。
よくある質問
- 製品の安全性は?
- 本製品は当社独自の種菌を使用し、製造工程において長時間にわたる高温発酵を行うことで、食中毒菌など人体に害を及ぼす菌の増殖を抑制していることが解析試験によりわかっています。また最終製品の全てのロットにおいて、第三者機関による食品安全検査を実施し、大腸菌や食中毒菌として知られるセレウス菌・サルモネラ菌・緑膿菌・黄色ブドウ球菌が陰性であることを確認して出荷しております。製造工場のHACCPに沿った衛生管理については食品検査および食品衛生管理のエキスパートである株式会社クロックワークのサポートを受けて取り組んでいます。
- ビフィズス菌や乳酸菌との違いは?
- ビフィズス菌や乳酸菌は腸内環境を整える善玉菌として知られています。腸内環境改善に関するビフィズス菌や乳酸菌製品は、1〜数種類の菌種が使用されています。最新の研究から、SOILcureは土壌由来の50種類以上の菌を含有していることがわかっています。腸内フローラを健康に保つためには特定の菌種を増やすのではなく、多様性を高く保つことが重要だと認知されてきています。SOILcureは、特定の善玉菌だけではなく菌の多様性に着目したプロバイオティクスサプリメントであることが特徴です。
1週間お試しパッケージからの
リピート率

※自社調べ 2025年7月現在

※1 自社調べ(2023年7月時点) ※2 ★評価は自社ECサイトおよび主要ECショップでの口コミ評価の平均(2023年7月時点)から算出
- 土壌菌群の「菌の多様性」に着目
- 「短鎖脂肪酸生産菌群」が
生きて腸まで届く
- 1日分(1粒200mg)の
カロリーは約0.9kcalだから、
糖質制限中の方も安心!
- 素材がシンプル♪(※1)
賦型剤(※2)・保存料不使用
※1:各商品の原材料は商品ページに記載しています。※2:サプリメントを製造する際に成形型等の目的で使用される添加物のこと
SOILcure(ソイルキュア)で
1日たったの1粒で、
あなたの今日の菌活は完了!
※摂取目安量となります。
1日分(1粒200mg)の
カロリーは約0.9kcal
SOILcureおすすめの
活用方法・シーン

- 無くなり次第終了の、
限定300セット
キャンペーンです!
まだ「これだ!」という
菌活アイテムに巡り会えていないそこのアナタへ
30日間お試しの
スペシャル
オファー
まずは30日、
1日1粒(摂取目安量)
お試しください

- SOILcureカプセル
- (30粒入り/30日分)
- ※摂取目安量1日1粒を召し上がった場合
- 通常価格
- 6,458円(税込)
- 特別30日間お試し価格
- 4,500円(税込)
商品一覧



プレバイオティクス素材をプラス
さしくさカプセル(30粒入り/目安:30日分)
6,458円(税込・送料込み)〜
定期購入で更にオトク♪
4,860円(税込・送料込み)で、
OFF!






健康の維持・増進に多くのメリットがある物質として注目されているのじゃ!